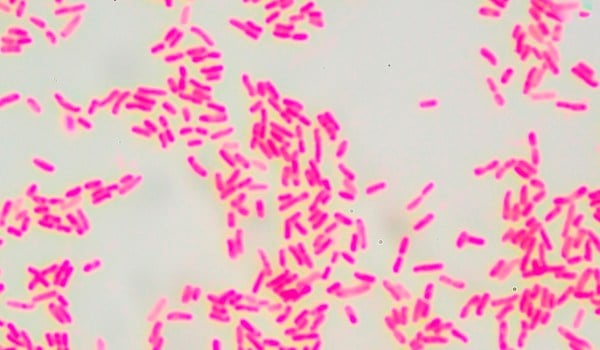
Actualización multidisciplinar en enfermedades infecciosas por grampositivas

Actualización multidisciplinar en enfermedades infecciosas por grampositivas
Datos generales
Esta actualización multidisciplinar aborda las últimas investigaciones y avances clínicos en el manejo de las enfermedades infecciosas por grampositivas. Se revisan aspectos clave como la epidemiología, la patogénesis, el diagnóstico, el tratamiento y la prevención de estas infecciones, con un enfoque en la interdisciplinariedad y la colaboración entre diferentes especialidades médicas. Los expertos en el campo analizan estrategias terapéuticas novedosas, resistencia a los antibióticos, vacunas en desarrollo y recomendaciones para la práctica clínica. Esta actualización es imprescindible para profesionales de la salud involucrados en el manejo de enfermedades infecciosas.
Metodología Innovadora
En Formación Alcalá, apostamos por las técnicas y herramientas educativas más actuales para que tu experiencia de aprendizaje sea realmente dinámica, motivadora y efectiva.
Flexibilidad y Acceso 24/7
Ponemos a tu alcance todos los materiales y recursos online para que puedas aprender a tu ritmo y desde donde quieras, en cualquier momento del día.
Equipo docente especializado
Nuestro equipo docente está formado por profesionales apasionados y comprometidos que te acompañarán durante todo el proceso formativo, siempre dispuestos a ayudarte.
Titulación con validez en todo el territorio nacional
Tu esfuerzo merece reconocimiento: da un paso más en tu formación con una titulación que impulse tu carrera.
Certificación
CFC Comisión de formación continuada
El Actualización multidisciplinar en enfermedades infecciosas por grampositivas está acreditado con 30 Horas, 4.2 Créditos por la prestigiosa CFC Comisión de formación continuada. Registrada con el Número 336329-871/25 Es el órgano colegiado de las Administraciones Públicas, adscrito a la Comisión de Recursos Humanos del Sistema Nacional de Salud, creado con el fin de armonizar el ejercicio de las funciones que las administraciones sanitarias públicas y demás instituciones y organismos ostentan en materia de formación continuada así como de coordinar las actuaciones que se desarrollen en dicho campo.

Sus cursos son válidos en bolsas y oposiciones a nivel nacional. Para una información más amplia y concisa, consulte con su convocatoria o su bolsa. Este organismo expide sus diplomas en créditos y horas.
¿Tienes alguna duda?
Llámanos o escríbenos por WhatsApp, estamos aquí para ayudarte.

Plan de estudios
Requisitos de acceso
- Copia del DNI, TIE o Pasaporte.
Plazo inscripción
La inscripción en esta actividad permanecerá abierta hasta final de edición.
Evaluación
- 95 Preguntas tipo test de 4 respuestas.
- 6 Supuestos.
Es obligatorio realizar una encuesta para finalizar la actividad.
Para superar el curso será necesario obtener una calificación de 7,5 sobre 10.
En caso de no superar el total de las evaluaciones conjuntamente, el alumno dispone de una segunda oportunidad sin coste adicional.
A tener en cuenta
Este programa formativo online / a distancia está dirigido a todo aquel personal de:
- Medicina.
- Farmacia.
- Biología.
- Enfermería.
- T. S. Laboratorio.
- TCAE.
- T. Farmacia.
Objetivos generales:
El alumno adquirirá las habilidades, destrezas y conocimientos suficientes para:
- Comprender los aspectos microbiológicos y clínicos de las infecciones causadas por bacterias grampositivas: Los asistentes adquirirán conocimientos sobre la epidemiología, patogenia, diagnóstico y tratamiento de las infecciones provocadas por Staphylococcus, Streptococcus, Enterococcus, Bacillus y otras bacterias grampositivas, incluyendo aquellas de importancia en situaciones de bioterrorismo.
- Actualizarse en las mejores prácticas de diagnóstico y tratamiento de las infecciones por bacterias grampositivas, con un enfoque en la detección precoz y el manejo clínico adecuado, tanto en el entorno hospitalario como en el comunitario.
- Desarrollar competencias en la prevención y control de infecciones bacterianas resistentes a antibióticos, con el fin de mejorar los resultados en la atención de pacientes y contribuir a la lucha contra la resistencia antimicrobiana.
- Identificar los riesgos asociados al manejo de patógenos de interés en bioterrorismo y aplicar protocolos de prevención y respuesta ante incidentes con sustancias biológicas y químicas.
Objetivos específicos:
- Distinguir entre las diferentes especies de bacterias del género Staphylococcus, como S. aureus, S. epidermis y S. saprophyticus, comprendiendo sus características microbiológicas, formas de transmisión, mecanismos de patogenicidad y abordajes terapéuticos específicos.
- Reconocer las infecciones causadas por estreptococos y enterococos, identificando los factores de riesgo, los síntomas clínicos y las estrategias de diagnóstico, así como los tratamientos efectivos y medidas de prevención para infecciones como las producidas por S. pneumoniae y Enterococcus.
- Analizar las infecciones causadas por bacilos grampositivos, incluyendo Bacillus anthracis y Bacillus cereus, aprendiendo a identificar casos de infección a través de sus características clínicas y epidemiológicas, y aplicando tratamientos adecuados basados en la evidencia.
- Describir las infecciones causadas por otras bacterias grampositivas como Corynebacterium diphtheriae y Listeria monocytogenes, con especial atención a su diagnóstico diferencial y manejo clínico.
- Comprender las implicaciones de los patógenos de interés en bioterrorismo, como Bacillus anthracis, y las estrategias de prevención, diagnóstico y manejo ante incidentes con agentes biológicos y químicos.
- Aplicar técnicas de laboratorio para el diagnóstico microbiológico adecuado, reconociendo las herramientas más avanzadas y confiables para la identificación de bacterias grampositivas, así como los protocolos para el manejo y transporte de muestras en casos de sospecha de bioterrorismo.
- Evaluar las prácticas de uso racional de antibióticos en el tratamiento de infecciones por bacterias grampositivas, enfocándose en la reducción de la resistencia antimicrobiana y promoviendo un uso adecuado de los antimicrobianos tanto en el entorno clínico como comunitario.
- Colaborar de manera interdisciplinaria en la atención al paciente infectado por bacterias grampositivas, integrando conocimientos microbiológicos, clínicos, farmacológicos y de prevención, para garantizar un tratamiento eficaz y seguro.
| # | Fecha Inicio | Fecha Fin |
|---|---|---|
| 7 | 15/07/2026 | 27/08/2026 |
| 8 | 15/09/2026 | 27/10/2026 |
Temario
- Tema I. Género Staphylococcus.
- Tema II. Bacterias de los géneros Streptococcus y Enterococcus.
- Tema I. Bacterias del género Bacillus.
- Tema II. Otros Bacilos Gram positivos.
Metodología
Tu formación a distancia se adapta a ti gracias a nuestra plataforma online. Podrás acceder al contenido, descargar materiales y realizar tu formación desde cualquier lugar, sin barreras.


